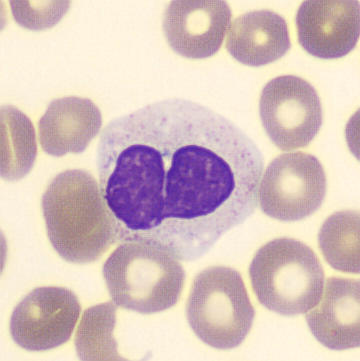
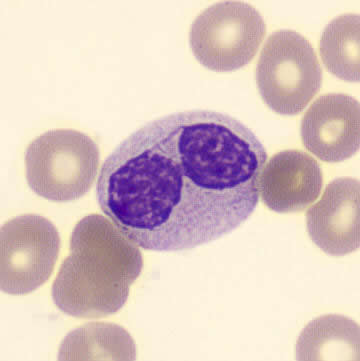
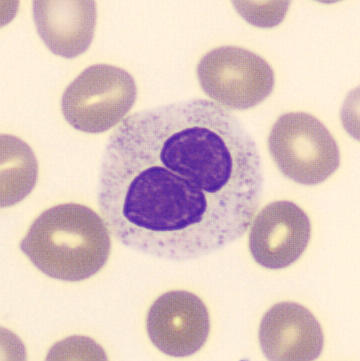
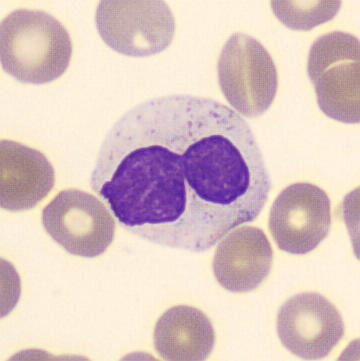
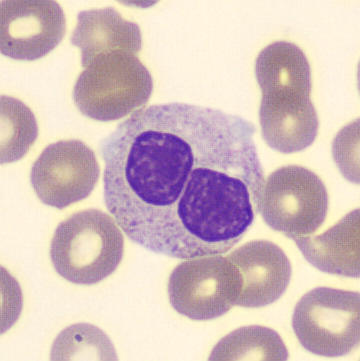
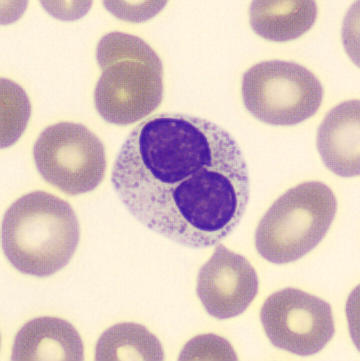
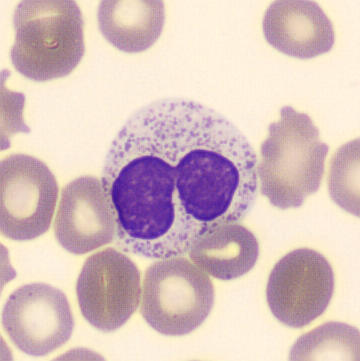
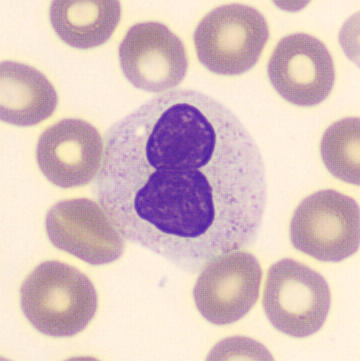

Pelger-Huët-Anomalie
Synonyme: Pelger, Pseudo-Pelger, Erworbener Pelger-Huët, Pince-nez
Pelger-Huët ist eine relativ seltene, autosomal-dominante Störung, bei der neutrophile und eosinophile Granulozyten aufgrund einer Mutation im Lamin-B-Rezeptor-Gen nur zweilappige Kerne haben. Die Granulozyten homozygoter betroffener Patienten können infolgedessen in ihrer Funktion beeinträchtigt sein.
Viel häufiger ist diese Anomalie jedoch bei hämatologischem Stress aufgrund von Infektionen, Traumata oder bösartigen Erkrankungen zu beobachten. Man spricht dann von pseudo Pelger-Huët. Die beiden Formen sind leicht voneinander abzugrenzen, da bei Pseudo-Pelger-Huët immer normale Granulozyten zu finden sind.